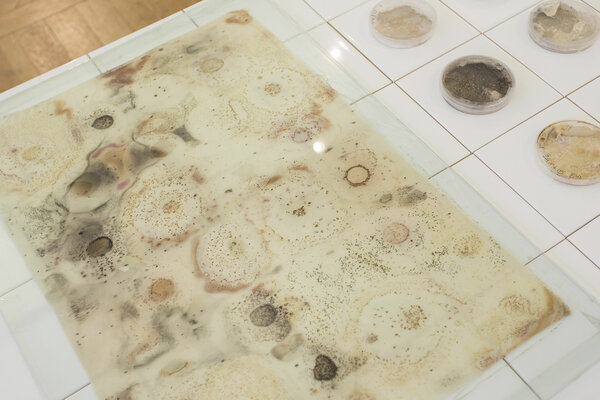

Textile design is a little odd in some regards, as the product is generally not yet the finished product. It only becomes finished when other designers decorate rooms with the material, design clothes with it or use it to cover car seats.
Above all, textile design is a very varied field – a material is not just the sum of various properties, but is also a complicated interplay of different characteristics that all have an impact. It can best be compared to a fabric itself: the individual fibres are not decisive, and the overall amount of it present is not critical either; instead, what is important is the way the fibres go together and the substance, colour and characteristics they have. It is this combination that ultimately decides on both function and quality.
Textile design is very complex, but not at all complicated. You can touch, feel and look at the material, and even smell and listen to it too! It is emotional and functional at the same time.
Textile design presents conceptual challenges that have to meet certain practical requirements in the context of the demands that society places on design. This involves historical references, current factors and visionary ideas too. On the other hand, the course requires very detailed specialist knowledge in all disciplines that deal with surfaces in order to be able to meet challenges in a case-specific manner.
Prof. Bettina Göttke-Krogmann